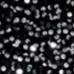

LUCCE wholesale products
LUCCE wholesale products
LUCCE wholesale products
Find products for your store from thousands of brands.
Unlock wholesale pricingAbout LUCCE
LUCCE is a women's ready-to-wear brand that embodies modernity, trendiness, and accessibility. It stands out for its commitment to offering collections inspired by the latest trends. Every week, new pieces inspired by the latest trends enrich our collections. Find us at the Fashion Center in Aubervilliers, on the outskirts of Paris.